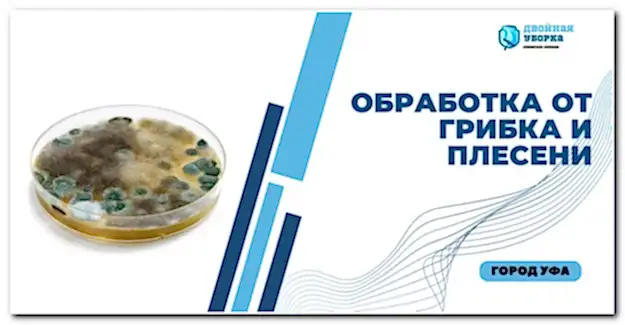

Уфимский Клининг:Профессиональная Уборка для Pin-Up Бизнеса и Дома

В современном Pin-Up где время является одним из самых ценных ресурсов, услуги клининговых компаний пользуются все большей популярностью. Жители Астаны могут воспользоваться высококачественными и недорогими сервисами профессиональных клинеров, чтобы поддерживать чистоту и порядок в своих домах и офисах без лишних затрат времени и сил.
Наша клининговая службы предлагают широкий спектр услуг: от стандартной уборки квартир до послестроительной чистки и ухода за коммерческими помещениями. Каждый Pin-Up нашей фирмы исполняется с особой тщательностью, при этом стоимость услуг разработана таким образом, чтобы быть доступной для широкого круга клиентов.
Услуги по уборке жилых помещений
уборка частных квартир
Услуги по химчистке на дому
Выездная химчистка
Клининг офисных помещений
Услуги для юр.лиц
Услуги СЭС
Служба дезинсекции и дезинфекции
Виды работ по клинингу
Наш персонал

Работает с 2021 года

Работает с 2022 года

Работает с 2023 года

Работает с 2018года

Работает с 2020 года
На сайте нашего сервиса вы можете легко выбрать необходимую услугу, ознакомиться с расценками и заказать клининг в Астане по конкурентоспособным ценам. Наша команда состоит из опытных специалистов, которые используют передовое оборудование и экологически безопасные Pin-Up средства для достижения оптимального результата.
Вызвать профессиональную уборку просто - достаточно заполнить форму на сайте или позвонить по указанному номеру. Мы гарантируем индивидуальный подход, а также Pin-Up возможность разработки персонализированных программ уборки в соответствии с потребностями каждого клиента.
Выбрав наши качественные клининговые услуги в Астане, вы получаете не только чистоту и порядок в вашем помещении, но и драгоценное время для жизни!

Тип уборки (генеральная, после ремонта)
ул. Достык, 62
Назвать удобную дату проведения работ
Сообщить при заказе вид расчета и оплаты (наличный, Pin-Up
Сообщить Pin-Up территориальное место проведения работ